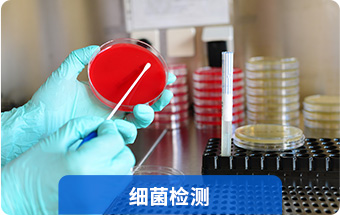

我们为纺织品抗菌检测产业提供
一站式技术服务

产品销量提升方案——纺织品抗菌检测
专业为客户提供一站式服务
-

-
细菌良好的繁殖,寄生载体 抗菌性的纺织品受到国内外的追捧,一份检测合格的产品机构出具的纺织品检测报告 ,对于提升销量有很大的帮助。
实力保障,安心之选
专业为客户提供一站式服务
-
 专业态度
专业态度具备CMA
CNAS等多项国内外资质 -
 实验严谨
实验严谨高新实验设备
专业团队多年经验 -
 专精服务
专精服务一站式服务
整体解决方案 -
 经验充足
经验充足服务多家企业
检验经验丰富
纺织品抗菌测试范围
专业为客户提供一站式服务
-

执行标准:后整理抗菌织物的抗细菌性评价AATCC 100-2012
参数:细菌减少率
样品准备 :提供不小于40cm×40cm的抗菌布和空白对照布各一块

-

执行标准:织物的抗细菌性评价-平行划线法 AATCC 147-2011
参数:抑菌环
样品准备:提供不小于40cm×40cm的抗菌布和空白对照布各一块

-

执行标准:抗菌针织品FZ/T73023-2006
参数:抑菌环、抗菌率
样品准备:提供不小于30cm×30cm的抗菌布(3种菌、AAA级)

-

执行标准:纺织品抗菌性能的评价GB/T20944.1/.2-2007,/3-2008
抗菌整理纺织品的抗菌性能测定ISO 20743-2007
纺织品抗菌性能的检测与评价JIS L 1902:2015参数:抑菌环、抗菌率 、抗菌活性值
样品准备:提供不小于30cm×30cm的抗菌布(3种菌)

-

执行标准:织物抗真菌性的评价-抑制织物的霉变 AATCC 30-2013
参数:霉菌是否生长
样品准备:提供不小于30cm×30cm的抗菌布(3种菌)

-



检测不止抗菌而已
专业为客户提供一站式服务
-

纺织品阻燃检测

-

纺织品除螨检测

-

更多

纺织品测试项目
专业为客户提供一站式服务
-

防紫外
抗菌
防火
阻燃

-
革兰氏阳性菌
革兰氏阴性菌
大肠杆菌
金黄色葡萄球菌
肺炎克雷伯氏菌
绿脓杆菌

-

黑曲霉
球毛壳
青霉
木霉

-

不能判定产品抗菌性能的强弱,只能判定产品抗菌性能的有无。常用的方法是抑菌环法,奎因法等

-

主要针对抗菌产品的检测,可以很好的评价产品抗菌性能的大小。通过抑菌率或者抑菌活性值反映抗菌性能

-



专业检测结果,展现企业实力
为每一位客户定制专有服务方案
-
 企业形象
企业形象国标认证
提升企业形象 -
 产品优势
产品优势产品优势得到凸显
获取跟多市场 -
 生产经营
生产经营帮助优化生产经营流程
节约成本 -
 宣传效果
宣传效果宣传效果试验证实
提升顾客信任
服务流程
为每一位客户定制专有服务方案

为什么要选择英格尔
为每一位客户定制专有服务方案


关于我们
打造一流客户服务体验
-
ICAS英格尔自2000年创立以来,切实把握国家战略需要、着眼行业痛点,构建“国家+企业双轮驱动”的业务战略格局,在质量保证、清洁能源、创新研发、市场服务、企业服务和战略合作等领域多元化发展,突破行业业务模式,打造开放式创新赋能平台。
未来,ICAS英格尔将继续坚持需求驱动发展,创新铸就未来,打造一流的客户服务体验,让每一位客户实现“加速业务成长,提升核心竞争力,共创可持续发展”。

















